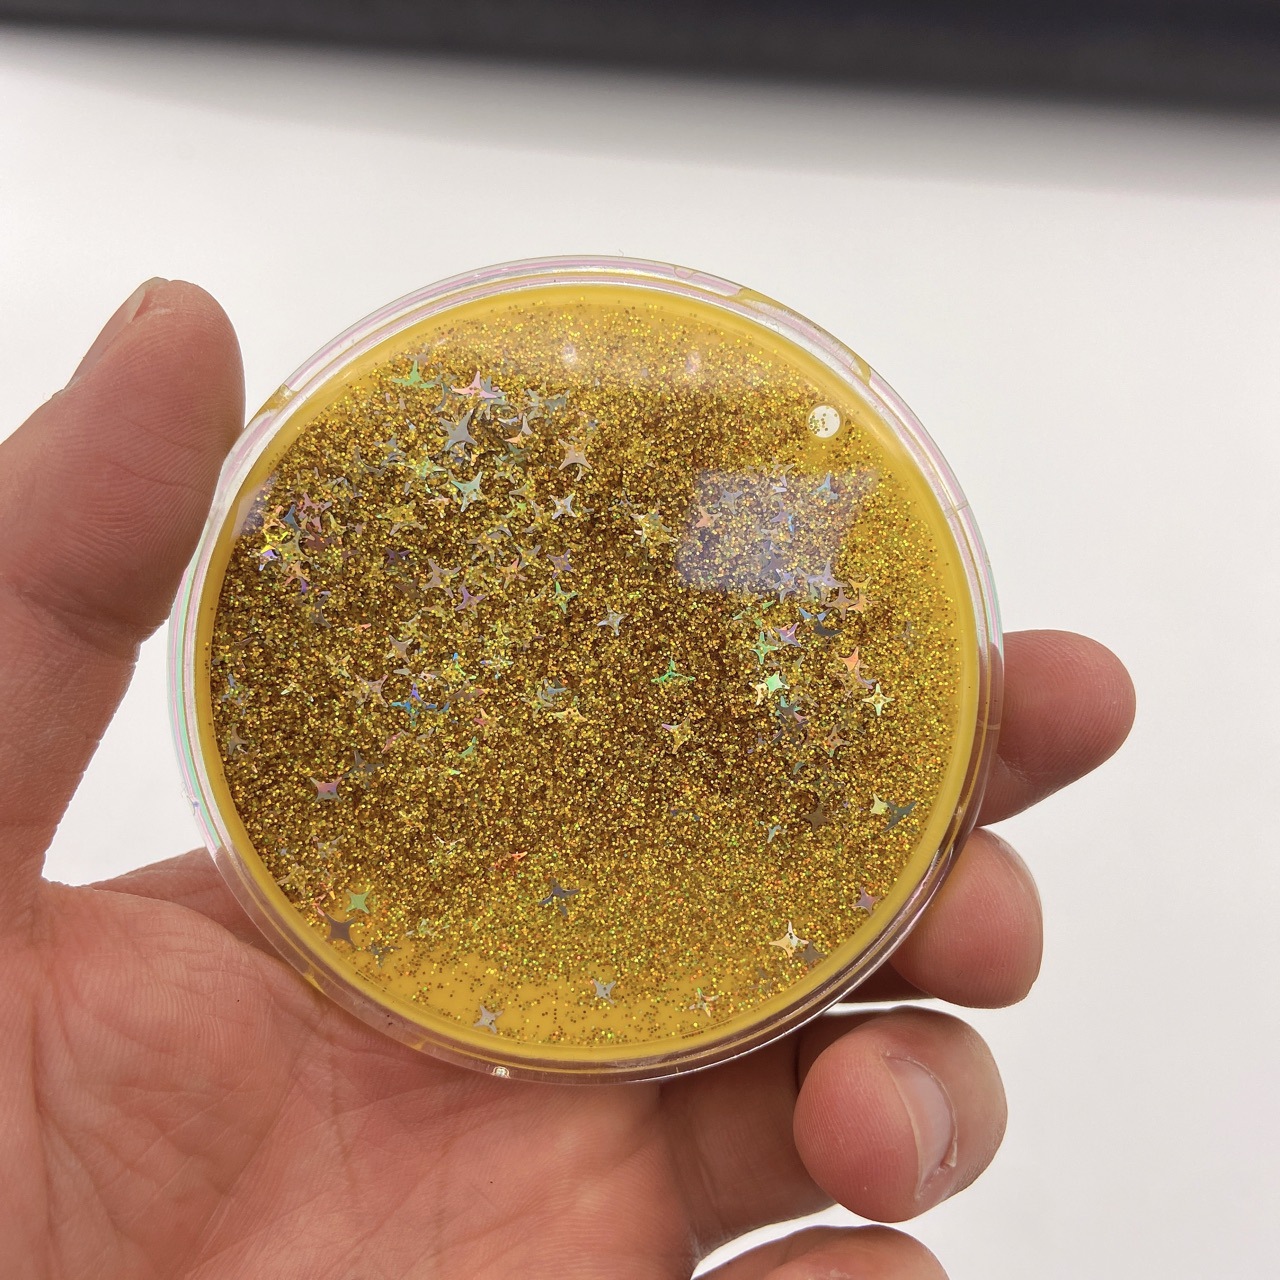

Круглая деталь из песка 68 мм, специальные верхние детали для маленьких зеркал, ювелирные аксессуары различных размеров с рисунками и образцами.
Продано за 30 дней:
500 шт.
Всего продаж:
0 шт.
Минимальное количество для заказа:
500 шт.
Круглая деталь из песка 68 мм, специальные верхние детали для маленьких зеркал, ювелирные аксессуары различных размеров с рисунками и образцами.
от 33.00 ₽ за 1 шт.
-21%
33.00 ₽
Доставка по Китаю включена в цену
Оптом
от 500 шт.
33.00 ₽
Описание

Характеристики
номер товара:
01
Виды переработанной продукции:
Настраиваемый
Ежедневная мощность обработки:
50000
Метод обработки:
в любом случае
Обрабатывающее оборудование:
5
Категории продуктов:
Другие игрушки
Есть ли видео-руководство по покупкам?:
нет
Категория игрушек:
другие игрушки
бренд:
Цзинмейда
Заниматься ли исключительно поставками товаров для трансграничного экспорта:
нет
Применимый возраст:
Молодежь (15-35 лет)
Обработка и настройка:
является
О продавце
Имя:
Оценка сервиса:
4.0
Оценка логистики:
3.8
Оценка споров и жалоб:
4.0
Оценка предложения:
4.3
Оценка консультации:
4.0
repeatPurchasePercent:
0.34502890173410405
afterSalesExperienceScore:
4.6

Круглая деталь из песка 68 мм, специальные верхние детали для маленьких зеркал, ювелирные аксессуары различных размеров с рисунками и образцами.
33.00 ₽
33.00 ₽








